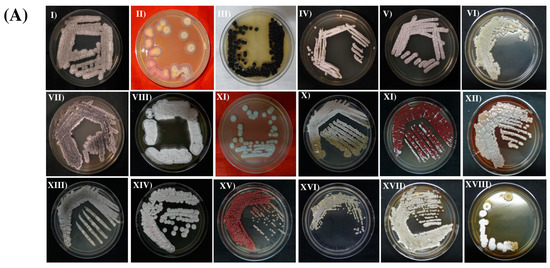

Abstract
Actinomycetia are known for their ability to produce a wide range of bioactive secondary metabolites having significant therapeutic importance. This study aimed to explore the potential of actinomycetia as a source of bioactive compounds with antimicrobial properties against multi-drug-resistant (MDR) clinical pathogens. A total of 65 actinomycetia were isolated from two unexplored forest ecosystems, namely the Pobitora Wildlife Sanctuary (PWS) and the Deepor Beel Wildlife Sanctuary (DBWS), located in the Indo-Burma mega-biodiversity hotspots of northeast India, out of which 19 isolates exhibited significant antimicrobial activity. 16S rRNA gene sequencing was used for the identification and phylogenetic analysis of the 19 potent actinomycetia isolates. The results reveal that the most dominant genus among the isolates was Streptomyces (84.21%), followed by rare actinomycetia genera such as Nocardia, Actinomadura, and Nonomuraea. Furthermore, seventeen of the isolates tested positive for at least one antibiotic biosynthetic gene, specifically type II polyketide synthase (PKS-II) and nonribosomal peptide synthetases (NRPSs). These genes are associated with the production of bioactive compounds with antimicrobial properties. Among the isolated strains, three actinomycetia strains, namely Streptomyces sp. PBR1, Streptomyces sp. PBR36, and Streptomyces sp. DBR11, demonstrated the most potent antimicrobial activity against seven test pathogens. This was determined through in vitro antimicrobial bioassays and the minimum inhibitory concentration (MIC) values of ethyl acetate extracts. Gas chromatography–mass spectrometry (GS-MS) and whole-genome sequencing (WGS) of the three strains revealed a diverse group of bioactive compounds and secondary metabolite biosynthetic gene clusters (smBGCs), respectively, indicating their high therapeutic potential. These findings highlight the potential of these microorganisms to serve as a valuable resource for the discovery and development of novel antibiotics and other therapeutics with high therapeutic potential.
1. Introduction
Antimicrobial drugs have revolutionized modern medicine by facilitating medical procedures, such as advanced surgical techniques, organ transplantation, and cancer treatment [1]. Rapid prevalence of antibiotic resistance has emerged as a major health concern, posing substantial risk to therapeutic interventions and resulting in approximately 700,000 deaths worldwide each year. In particular, the majority of these deaths were reported mainly in low- and low–middle-income countries (LMICs) [2]. Therefore, it is crucial to comprehend the primary pathogen–drug combinations that contribute to the current level of antimicrobial resistance (AMR) and their prevalence. In 2014, researchers estimated the occurrence of Escherichia coli and Klebsiella pneumoniae resistance to third-generation cephalosporins and carbapenems in 193 countries [3,4]. Six bacterial pathogens, namely E. coli, Staphylococcus aureus, Klebsiella pneumoniae, Streptococcus pneumoniae, Acinetobacter baumannii, and Pseudomonas aeruginosa, were responsible for over 250,000 deaths in 2019 and have been designated as priority pathogens by the World Health Organization (WHO) [3]. Globally, there have been high rates of resistance to antibiotics commonly used for treating bacterial infections, such as urinary tract infections (UTIs), sepsis, and sexually transmitted infections, observed in clinical settings [5]. Consequently, the treatment of antibiotic resistance has become increasingly challenging, necessitating the development of new antimicrobial drugs [6]. Thus, alternative strategies to mitigate antibiotic resistance have become an urgent requirement. In this context, the vast array of antimicrobial agents produced by actinomycetia plays a pivotal role in combating the antibiotic resistance crisis [7].
Actinomycetia, formerly known as actinobacteria, are filamentous bacteria that are Gram-positive and have a high Guanine and Cytosine (G + C) content in their genome. These bacteria are well known for their ability to produce bioactive secondary metabolites [8]. Among the actinomycetia, the Streptomyces species is particularly noteworthy, as they alone produce approximately 7600 bioactive compounds [9]. The genome of Streptomyces sp. typically contains 20 to 40 different types of biosynthetic gene clusters (BGCs). These gene clusters are responsible for encoding the biosynthesis of various chemical classes of compounds such as PKSs, NRPSs, terpenoids, siderophores, lanthipeptides, and several other natural products. These compounds have been found to possess diverse biological activities and are known to synthesize a wide range of antibiotics with significant pharmaceutical potential [10,11]. Indeed, natural products and their structural analogues have played a crucial role in pharmacotherapy, especially in the treatment of cancer and infectious diseases [12]. However, the utilization of natural products in drug discovery has traditionally posed challenges due to various technical barriers. These challenges include the isolation, screening, optimization, and characterization of bioactive compounds. Recent high-tech and scientific developments, including improved analytical tools, genome mining, engineering methods, and advancements in culturable methods, have addressed some of these issues and created new possibilities to consider natural products as potential drug leads, particularly for combating AMR [13]. The screening of microbial natural products has gained significant attention in the search for novel therapeutic agents, particularly in combating AMR [14,15].
Forest ecosystems are characterized by their rich biological diversity of plants, animals, and microorganisms and their intricate interdependence [16,17]. Due to this complex ecology, potent microbial taxa in the forest soil such as actinomycetia are often difficult to isolate and culture, making discovery of novel antibiotics challenging [18,19]. To overcome this limitation and unlock the potential of uncultivable actinomycetia, researchers are actively working on enhancing cultivation methods. These efforts involve mimicking the natural environment of actinomycetia, optimizing growth media, and creating specialized culturing conditions to stimulate the growth and production of bioactive compounds [20]. Natural product discovery has recently shifted its attention to less-explored natural habitats in search of novel culturable strains producing new antimicrobial compounds [7,21,22]. Hence, the untouched Indo-Burma belt of northeast India with diverse microflora earns special importance in this regard [7]. Furthermore, the climatic conditions of the state of Assam with a diverse range of natural ecosystems, including forests, grasslands, and wetlands, serve as a suitable habitats for various microbial communities [23].
The present study aimed to explore the potential of actinomycetia in the PWS and DBWS as a source of new antimicrobial compounds to combat MDR pathogens. A total of 65 actinomycetia isolates were obtained from these forest ecosystems, and among them, 3 were identified as the most potent actinomycetia strains. The antimicrobial compounds produced by the most potent strains were characterized by GC-MS analysis. Additionally, the strains showed low MIC values, indicating their effectiveness against MDR pathogens. Furthermore, whole-genome sequencing of the three potent Streptomyces strains was performed to investigate their potential to produce diverse groups of smBGCs with therapeutic potential. This study proposes that these pristine forest ecosystems may contain novel actinomycetia species with significant antimicrobial properties, also earning special importance for further research into the antimicrobial potential of the diverse microflora.
2. Materials and Methods
2.1. Isolation of Pathogens from Urine Samples and In Vitro Antibiotic Susceptibility Testing
The urine samples of infected patients were collected from the pathological department of Guwahati Neurological Research Center (GNRC), Guwahati, Assam, India. They were labeled with the date of collection and sample code. The urine samples were transferred to the laboratory on the same day they were collected. In this study, UTI Hi-chrome agar (HiMedia, Mumbai, India) was used for the selective isolation and identification of pathogens from urine cultures. Synthetic chromogenic enzyme substrates are used in chromogenic media for the identification of pathogenic species based on their enzymatic action. Colorless substrates produce distinctive colors when cleaved by pathogen-specific enzymes [24]. All urine samples were inoculated aseptically onto UTI Hi-chrome agar media using a sterile loop. The culture plates were examined after 24 h of incubation at 37 °C. The isolated pathogens were then examined for antibiotic susceptibility assay. The antibiotics tested were nalidixic acid (30 µg), ampicillin (10 µg), levofloxacin (5 µg), co-trimoxazole (25 µg), norfloxacin (10 µg), ciprofloxacin (5 µg), cefazolin (30 µg), and nitrofurantoin (300 µg). The assay was performed using the HiMedia antibiotic sensitivity disk (HiMedia, Mumbai), as per the manufacture’s instruction. Antibiotic sensitivity was assayed from the diameter of the inhibition zones. As per the CLSI manual 2020 [25], based on the zone diameters, test clinical isolates were noted as either resistant (R), intermediate (I), or sensitive (S). The pathogens that showed resistance to most of the antibiotics were selected as test pathogens for in vitro bioassay.
2.2. Soil Sample Collection Site and Isolation of Actinomycetia from the Soil Samples
Different locations of two protected forest ecosystems of Assam, PWS (26°12″–26°16″ N and 91°58″–92°05″ E) and DBWS (26.1177° N and 91.6494° E), situated in the northeastern part of India, were selected for the collection of soil samples (Figure 1). The soil is mainly composed of river alluvium, and the color of the soil ranges from reddish-brown to reddish-yellow. The soil is termed fertile clayey loam with silt. The rhizosphere soil samples were taken from the upper layer and 10 to 20 cm beneath the earth’s surface. The samples were collected in sterile zip lock bags and properly labeled with the date of collection and brought to the laboratory on the same day and stored at 4 °C until examined.
Figure 1.
Soil sample collection site: soil samples were collected from two poorly explored forest ecosystems of Assam, India; (1) PWS. (2) DBWS.
A serial dilution approach was used to isolate the actinomycetia from collected soil samples. A previously described, method [7] was followed to isolate actinomycetia from soil samples. A soil suspension from the collected soil sample was prepared with 5 g of soil in 100 mL of normal saline water (NaCl; 9 g/L), followed by incubation at 28 °C for 24 h with continuous shaking at 180 rpm. After allowing the mixtures to settle, sterile saline water was used to make dilutions up to 10−4, and then the dilutions were thoroughly mixed by vortex at maximum speed. For isolation, SA (Streptomyces Agar) and AIA (Actinomycetes Isolation Agar) media plates supplemented with amphotericin B (75 μg/mL) and rifampicin (2.5 μg/mL) were used. Amphotericin B and rifampicin were used against fungal and bacterial growth, respectively. Aliquots of 0.1 ml from each dilution were spread on the plates of isolation media and incubated at 28 °C and monitored after 48, 72, and 96 h. Streaking on GLM agar plate (Yeast extract, 3 g; malt extract, 3 g; peptone Type I, 5 g; starch, 10 g; agar, 20 g; distilled water, 1000 mL; pH 7.5) led to the purification of the actinomycetia isolate. The isolates were maintained in 20% glycerol at −80 °C. The morphology of the isolates was examined using scanning electron microscopy (SEM) [26].
2.3. Model Pathogens for In Vitro Antimicrobial Bioassay
Seven model pathogens were used for the in vitro antimicrobial bioassay: Gram-positive bacteria: (methicillin-resistant Staphylococcus aureus) MRSA (ATCC 43300); Gram-negative bacteria: Klebsiella pneumoniae (MTCC 3384), Pseudomonas aeruginosa (MTCC 741); yeast: Candida albicans (MTCC 227), and three MDR pathogens; Enterococcus faecalis (GNR7), Pseudomonas aeruginosa (GNR18), and Escherichia coli (GNR19). MTCC and ATCC strains were procured from Microbial Type Culture Collection, CSIR Institute of microbial technology cultures and HiMedia, Mumbai, respectively.
2.4. Evaluation of Actinomycetia against Model Pathogens and MDR Pathogens
A total of 65 actinomycetia isolates were selected for in vitro antimicrobial bioassay. Spot inoculation technique was used for the preliminary screening against different model pathogens on 5-day-old cultured GLM agar plate of actinomycetia isolates [7]. A clear zone was seen after 24–48 h of incubation at 37 °C and 28 °C for bacteria and yeasts, respectively. For secondary screening, the agar well diffusion method was followed [27]. The fermentation of the culture broth was performed by the method described previously [7]. A clear inhibition zone around the wells indicates that the test organism is sensitive to the corresponding broth. Each experiment was carried out thrice, and the mean value of the diameter of the inhibition zone (mm ± SE) was calculated.
2.5. Determination of Minimum Inhibitory Concentration (MIC)
The MIC of the ethyl acetate extract (EtAc) of three actinomycetia strains (EtAc-PBR1, EtAc-PBR36, and EtAc-DBR11) was examined by broth dilution method [7]. The concentration with no observable growth of the pathogen was noted as MIC.
2.6. Morphological Effect of Actinomycetia Isolate on Model Pathogen and MDR Pathogen
The antimicrobial effects of ethyl acetate extract of strain Streptomyces sp. PBR36 (EtAc-PBR36) on the cells of Candida albicans (MTCC 227) and Escherichia coli (GNR19) were investigated by SEM analysis [7].
2.7. Molecular Characterization
2.7.1. Genomic DNA Extraction and PCR Amplification of 16S rRNA Gene
The actinomycetia isolates having the most potent antimicrobial activity against the model pathogens and MDR pathogens were selected for molecular identification. Nucleopore gDNA Fungal Bacteria Mini Kit (Genetix, New Delhi, India) was used for the extraction of DNA from the potent actinomycetia isolates. Universal primers, 27F (5′-AGA GTT TGA TCC TGG CTC AG-3′) and 1492R (5′-GGT TAC CTT GTT ACG ACT T-3′), were used for the amplification of 16S rRNA gene [28]. The reactions were executed in a Proflex PCR System (Applied Biosystems, Waltham, MA 02451, USA) in a total volume of 50 μL, consisting of 1.0 μL genomic DNA (10 ng), 0.2 μL of each primer (10 μM), 1×Taq DNA polymerase buffer (2.5 U), 0.2 mM of each dNTP, and 1 U Taq DNA polymerase enzyme. PCR was performed under the following conditions: initial denaturation at 94 °C for 5 min, followed by 35 cycles at 94 °C for 30 s, annealing at 52 °C for 30 s, 72 °C for 1 min, and a final extension at 72 °C for 7 min. Agarose gel (1.8% w/v) made in TAE buffer was used for the determination of PCR amplified products. A BioRad Gel Doc XR+ system (Hercules, CA, USA) was used for the visualization and imaging of the PCR bands. For molecular identification of the actinomycetia isolates, purified PCR products were sequenced by outsourcing to 1st BASE Laboratories, Malaysia.
2.7.2. Molecular Identification and Phylogenetic Analysis
Phylogenetic analysis and calculation of pairwise sequence similarities of the actinomycetia isolates based on 16S ribosomal RNA gene were carried out using Nucleotide BLAST (Basic Local Alignment Search Tool) [29]. The partial 16S ribosomal RNA gene sequences were submitted to NCBI Gene Bank database. 16S rRNA sequences were aligned using MUSCLE and subjected to phylogenetic analysis by maximum likelihood method using MEGA X (windows ×64 version) [30] with 1000 bootstrap steps and Tamura-Nei distance model [31].
2.7.3. Detection of Secondary Metabolite Synthesis Genes (NRPS and PKS-II)
PCR screening for PKS-II and NRPS biosynthetic genes was carried out using specific primers. PKS-II gene was amplified using degenerate primers KSαF (5′-TSG CST GCT TCG AYG GCS ATC-3′) and KSβR (3′-TCG CCG BAA GCC GCC NAA GGT-5′). NRPS genes were amplified using primers A3F (5′-GCS TAC SYS ATS TAC ACS TCS GG-3′) and A7R (5′-SAS GTC VCC SGT SCG GTA S-3′) [32]. PCR reactions were carried out in Proflex PCR System (Applied Biosystems, USA) in a final reaction volume of 50 µL consisting of template DNA (50 ng), 1×Taq DNA polymerase buffer, MgCl2 (1.5 mM), each dNTP (0.2 mM), 1 U Taq DNA polymerase enzyme, and each primer (0.2 µM). The amplified products for PKS-II and NRPS were evaluated in 1.8% (w/v) agarose gel made in 1×TAE buffer. The PCR bands were examined under UV light and documented using a BioRad Gel Doc XR+ system (Hercules, CA, USA).
2.8. Gas Chromatography–Mass Spectrometry (GC-MS) Analysis
GC-MS was performed to identify the chemical constituents present in EtAc-PBR1, EtAc-PBR36, and EtAc-DBR11 by the method described previously [7]. The peaks representing individual compounds were identified by matching the mass spectra with the National Institute of Standards and Technology (NIST), USA library.
2.9. Whole-Genome Sequencing Assembly and Annotation
Nucleopore gDNA Fungal Bacteria Mini Kit (Genetix) was used for the extraction of genomic DNA from the three most potent actinomycetia strains; Streptomyces sp. PBR1, Streptomyces sp. PBR36, and Streptomyces sp. DBR11. The genomic DNA library construction was performed using the Illumina Nextera DNA XT (Macrogen, Seoul, Republic of Korea). The paired-end illumina reads were quality checked using MultiQC, followed by adapter removal and trimming by Trimmomatic v 0.39 [33]. The genome was assembled using unicycler v 0.5.0 as a SPAdes-optimiser [34]. The assembly was then analyzed using quast v 5.2.0 [35]. The genome coverage and completeness were determined using BUSCO [36]. Furthermore, the genome assembly completeness was analyzed using the BUSCO tool [37]. The annotation of the genome and taxonomic identification was conducted using prokaryotic genome annotation pipeline (PGAP) and the average nucleotide identity (ANI) method [38,39]. The annotated contigs were processed in NCBI genomic workbench and submitted to NCBI using the genome submission wizard. The genome-wide identification, annotation, and analysis of smBGCs was performed using the antiSMASH (antibiotics and secondary metabolite analysis shell) tool (https://antismash.secondarymetabolites.org/ (accessed on 30 March 2022)) [40], and the results were compared with the MIBiG (Minimum Information about a Biosynthetic Gene cluster) gene cluster database. Rapid annotation subsystem technology (RAST), version 2.0 (https://rast.nmpdr.org/ (accessed on 5 April 2022)), was used to identify the virulence or antibiotic-resistant encoding genes [41].
2.10. Statistical Analysis
All experiments were performed in biological triplicate. The data were stated as the mean ± standard error of the mean. One-way ANOVA was performed in SPSS statistic 26.0 for the variation of inhibition among different actinomycetia strains with the 3 groups (3 MDR pathogens). A p < 0.001 was measured as significant. The test for variances within the strains in the antimicrobial assay is adjusted for all pairwise comparisons using the Bonferroni correction.
3. Results
3.1. Isolation and In Vitro Antibiotic Susceptibility Profile of MDR Pathogens
A total of 28 cultures were examined from the urines of infected patients, and 19 pathogens were isolated. E. coli was found to be the most prevalent pathogen in the urine samples, accounting for 42.10% of the identified pathogens, followed by Enterococcus faecalis (31.57%), Klebsiella pneumoniae (10.52%), Candida albicans (10.52%), and Pseudomonas aeruginosa (5.26%) (Figure 2A). All of the isolated pathogens exhibited resistance to the tested antibiotics. The results of the antibiotic susceptibility profile are shown in Table S1. Out of nineteen isolated pathogens, seven showed resistance against all the antibiotics used in the antibiotic sensitivity studies and characterized as MDR isolates. Notably, five of the MDR isolates were E. coli. An increasing incidence of drug-resistant E. coli and Enterococci was observed. (Figure 2B).
Figure 2.
Isolation of pathogens from urine: (A) Most abundant pathogens isolated from culture plate, such as Escherichia coli (GNR19) on UTI Hi-chrome agar media. (B) In vitro screening of pathogens against antibiotics based on sensitivity disk (HiMedia), such as conducted for (I) Escherichia coli (GNR19); (II) Enterococcus faecalis (GNR7); and (III) Pseudomonas aeruginosa (GNR18).
3.2. Isolation and In Vitro Antimicrobial Bioassay of Actinomycetia against Model Pathogens and MDR Pathogens
The selective isolation process resulted in sixty-five morphologically different actinomycetia isolates from the soil samples of two poorly explored forest ecosystems. Thirty-nine actinomycetia were obtained from PWS and twenty-six from DBWS (Figure 3A). The SA media (n = 43) yielded more actinomycetia isolates, followed by AIA media (n = 22). The actinomycetia isolates were identified based on their morphological characters, such as colony morphology, color of substrate and aerial mycelium, color of diffusible pigments, and structure of hyphae (Figure 3B; Table S1).
Figure 3.
Isolation of actinomycetia from soil samples: (A) Pure culture plates of actinomycetia strains in GLM media. (I) Streptomyces sp. DBR11. (II) Streptomyces sp. PBR21. (III) Actinomadura sp. DBR17. (IV) Streptomyces sp. PBR30. (V) Streptomyces sp. DBR3. (VI) Streptomyces sp. PBR1. (VII); Streptomyces sp. DBR5. (VIII); Streptomyces sp. PBR11. (IX) Streptomyces sp. PBR19. (X) Streptomyces sp. PBR4. (XI) Streptomyces sp. DBR16. (XII) Streptomyces sp. PBR36. (XIII); Streptomyces sp. DBR1, (XIV); Streptomyces sp. PBR19, (XV) Streptomyces sp. DBR10. (XVI) Nonomuraea sp. DBR25. (XVII) Streptomyces sp. DBR4. (XVIII) Streptomyces sp. PBR35. (B) SEM image showing rectiflexibiles-type spore chains. (I) Streptomyces sp. DBR11. (II) Streptomyces sp. PBR1. (III) Streptomyces sp. PBR36.
Out of 65 actinomycetia isolates, 19 strains (29.23%) showed antimicrobial activity against at least 1 of the 4 model pathogens and 3 MDR pathogens. A total of 15 strains (78.9%) exhibited positive activity against MRSA (ATCC 43300), where Streptomyces sp. PBR1 exhibited a maximum zone of inhibition of 30.67 ± 0.33 mm. A total of 11 strains (73.33%) showed antimicrobial activity against Klebsiella pneumoniae (MTCC 3384), with the highest zone of inhibition being 35 ± 0.58 mm by Streptomyces sp. PBR1. The growth of Pseudomonas aeruginosa (MTCC 741) is inhibited by 15 actinomycetia strains (78.94%), with a maximum zone of inhibition of 34.33± 0.33 mm by Streptomyces sp. DBR10. Fifteen strains exhibited significant antifungal activity against Candida albicans (MTCC 227) with a maximum zone of inhibition of 47.00 ± 1.00 mm by Streptomyces sp. PBR11. Results of antimicrobial activity by spot inoculation and well diffusion method are shown in Figure 4. Furthermore, six actinomycetia strains, viz. Streptomyces sp. PBR36, Streptomyces sp. DBR10, Streptomyces sp. DBR11, Nonomuraea sp. DBR25, Streptomyces sp. PBR1, and Streptomyces sp. PBR35, can inhibit all the model pathogens, including MDR pathogens (Tables S3 and S4). The three most promising actinomycetia strains identified as Streptomyces sp. PBR1, Streptomyces sp. PBR36, and Streptomyces sp. DBR11 exhibited broad-spectrum antimicrobial activity, with the maximum inhibition against three MDR pathogens. The values that do not share the same superscript are significantly different at p < 0.001, as shown in Tables S3 and S4.
Figure 4.
In vitro antimicrobial bioassay of actinomycetia extracts against model pathogens and MDR pathogens: (A) Antimicrobial activity by spot inoculation (I,II) and well diffusion method (III–V) against model pathogens: (I) Candida albicans (MTCC 227). (II,III) MRSA (ATCC 43300). (IV) Klebsiella pneumonia (MTCC 3384); (V) Pseudomonas aeruginosa (MTCC 741). (B) Bioactivity of fermentation broth of actinomycetia isolates against model pathogens, based on triplicate experiments. (C) Antimicrobial activity by well diffusion method against MDR pathogens: (I,II) Pseudomonas aeruginosa. (III–V) Enterococcus faecalis. (VI–VIII) Escherichia coli. (D) Bioactivity of fermentation broth of actinomycetia isolates against 3 MDR pathogens, based on triplicate experiments, against: GNR7; Enterococcus faecalis; GNR18; Pseudomonas aeruginosa; and GNR19; Escherichia coli.
3.3. Minimum Inhibitory Concentration (MIC) Assay
MIC values of ethyl acetate extract (EtAc) of the three strains PBR1, PBR36, and DBR11 ranged from 50 to 0.097 µg/mL against three pathogens, namely MRSA, Escherichia coli GNR19 (clinical isolate), and Candida albicans, were determined by broth dilution technique. EtAc-PBR1 showed the lowest MIC of 0.195 µg/mL against MRSA, whereas the highest value was recorded against Escherichia coli GNR19 (3.125 µg/mL). EtAc-PBR36 showed the lowest MIC of 0.097 µg/mL against Candida albicans, whereas the highest was recorded against both MRSA (0.781 µg/mL) and Escherichia coli GNR19 (0.781 µg/mL). EtAc-DBR11 exhibited the lowest MIC of 0.195 µg/mL against Candida albicans, whereas the highest value was noted against Escherichia coli GNR19 (12.50 µg/mL) (Table 1). According to CLSI, 2020 recommendations for MIC of levofloxacin, Escherichia coli (GNR19) was found to be resistant to EtAc-DBR11 (MIC: 12.50 µg/mL), since ≤2 µg/mL was taken as susceptible, ≤4 µg/mL as intermediate, and ≥8 µg/mL as resistant. A 10% DMSO was used as a control and had no activity on the model pathogens.
Table 1.
MIC (µg/mL) of the ethyl acetate extract of three potent actinomycetia strains by broth dilution method.
A considerable variation in the morphology was observed when the cells of MDR pathogen Escherichia coli (GNR19) and Candida albicans (MTCC 227) were treated with 1 × MIC EtAc-PBR36 (Figure 5). SEM analysis revealed that the treated cells were deformed and shrunk due to the loss of their cell integrity. However, actual cell morphology with intact cell surface was observed in the control cells.
Figure 5.
SEM image showing the effects of ethyl acetate extract of PBR36: (I,III) without treatment; (II,IV) treatment against Candida albicans MTCC 227 and Escherichia coli (GNR19), respectively, with 1 × MIC EtAc-PBR36. Arrow line denotes ruptured cells after treatment.
3.4. Molecular Characterization and Phylogenetic Analysis of Actinomycetia Isolates Using 16S rRNA Sequences
16S ribosomal RNAs of 19 potent actinomycetia isolates were sequenced and submitted to the NCBI GenBank database with accession numbers MH922849-MH922864, MN069557, MH718314, and MK981152. The 16S rRNA gene sequences of the actinomycetia strains revealed sequence similarity percentage within 92–100% upon BLAST homology search in EzTaxon [https://www.ezbiocloud.net (accessed on 11 February 2021)]. Two actinomycetia strains, Streptomyces sp. PBR11 (GenBank accession no. MH718314, 1370 bp) and Streptomyces sp. PBR19 (GenBank accession no. MH922862, 1348 bp), exhibited very low sequence similarity to their closest Streptomyces sp. PBR11 showed 92.91% sequence similarity to their closest hit, while Streptomyces sp. PBR19 displayed a maximum sequence similarity of 93.96. Based on the partial 16S rRNA sequences, all 19 actinomycetia strains were taxonomically divided into 4 different genera. The genus Streptomyces (n = 16) was found to be dominant, followed by Nocardia (n = 1), Actinomadura (n = 1) and Nonomuraea (n = 1) (Table S5).
Maximum likelihood analysis of 16s rRNA gene sequences also revealed two major clusters, one with the subcluster containing Streptomyces species and another with rare actinomycetia, namely Nocardia, Nonomuraea, and Actinomadura. The strains PBR35, PBR11, PBR19, and PBR21 were distributed distinctly, indicating that they may be related to the distinct taxa within the genus Streptomyces (Figure 6).
Figure 6.
Phylogenetic tree of actinomycetia isolated from forest ecosystems and the closest type strains based on the 16S rRNA sequences: Sequences were aligned using MUSCLE and subjected to phylogenetic analysis by maximum likelihood method using MEGA X with 1000 bootstrap steps and Tamura–Nei distance model.
3.5. Detection of Biosynthetic (PKS-II and NRPS) Genes
Nineteen potent actinomycetia isolates were assessed for the presence of different antimicrobial BGCs. Seventeen strains (89.47%) of actinomycetia showed an expected band size for the PKS type II gene, whereas the NRPS gene was detected in six strains (31.57%). Six actinomycetia strains, viz. Streptomyces sp. PBR30, Streptomyces sp. PBR35, Nocardia sp. DBRX, Streptomyces sp. PBR1, Streptomyces sp. PBR36, and Streptomyces sp. DBR11, showed positive results for both BGCs, i.e., PKS-II and NRPS (Figure 7).
Figure 7.
Agarose gel electrophoresis of PCR amplified products of actinobacteria: (A) Amplification of NRPS gene using A3F/A7R specific primers. (B) Amplification of PKS-II gene using degenerate primers KSαF/KSβR.
3.6. Gas Chromatography–Mass Spectrometry Analysis
The chemical profiling of the three most potent actinomycetia strains was performed using GC-MS analysis. A total of 19 major chemical compounds were detected in the ethyl acetate extracts of the 3 strains based on their molecular weight and retention time by comparing their mass spectra with the NIST database. In the ethyl acetate extract of Streptomyces sp. PBR1, i.e., EtAc-PBR1, nine major chemical compounds were detected, namely 5-amino-6-methoxy-8-nitroquinoline, isonipecotic acid, N-(3-fluoro-5-trifluoromethylbenzoyl)-, eicosyl ester, acetic acid, ydrazine-, ethyl ester, 4-bromo-2-trifluoromethylphenyl isothiocyanate, haloperidol, TMS derivative, spiro [5.5] undecane, 1-methylene, 9-acridanone, 1-ethoxy-3-methoxy-, 10-methyl-, 1-anthracenyl-2-pyridyl ketone, and fluoxymesterone. In EtAc-PBR36, four chemical compounds, resibufogenin, o-veratramide, 5-dicyanomethylene-9-diethylamino-6-fluorobenzo[a] phenoxazine and lanostan-3. β. -ol, 11. beta. 19-epoxy, were identified. Moreover, six major compounds, 2-(4-bromo-phenyl)-indolizine, 2-bromo-N-[4-bromo-2-(2-bromo-benzoyl)-phenyl]-acetamide, D: A-friedooleanan-3-ol, (3. α.), cyclopentanecarboxylic acid, 1-(4-ethoxy-4-oxo-2-butenyl)-2-oxo-, ethyl ester, L-Cysteine, N-acetyl-, methyl ester, acetate, and desflurane, were detected in the EtAc-DBR11 strain. Most of the detected compounds were reported to exhibit anticancer, antimicrobial, antiviral, antimalarial anti-inflammatory, and antituberculosis activities (Table 2A–C). The chemical structures of the identified compounds are shown in Figure S1.
Table 2.
Chemical compounds detected in the three Streptomyces sp. strains by GC-MS analysis: (A) Chemical compounds detected in Streptomyces sp. PBR1. (B) Chemical compounds detected in Streptomyces sp. PBR36. (C) Chemical compounds detected in Streptomyces sp. DBR11.
3.7. Genome Structure of Three Actinomycetia Strains
Genomic libraries of the three most potent actinomycetia strains were constructed using a Nextera XT DNA library preparation kit (Illumina Inc., Macrogen, Seoul, Republic of Korea). The genomic DNA was sequenced by the illumina HiSeq platform, using paired-end reads (150 bp). The de novo assembly of the sequences was annotated by prokaryotic genome annotation pipeline (PGAP). The assembled genome size of Streptomyces sp. DBR11 was 8,076,963 bp with G + C content of 72.09%. In the case of Streptomyces sp. PBR1, the assembled genome size was 9,557,226 bp with G + C content of 71.75%, and the complete genome of Streptomyces sp. PBR36 was found to be composed of 7,334,189 bp with G + C content of 72.82%. The complete genome sequences of the three actinomycetia strains were deposited at NCBI under WGS accession numbers JAMOLN000000000, JAMOLM000000000, and JAMOLO000000000 and BioProject number PRJNA834923. The WGS accessions, assembly statistics, and genome coverage are listed in Table S6.
3.8. Identification of Biosynthetic Gene Clusters and Antibiotic Resistant Genes
The secondary metabolites of three actinomycetia strains, Streptomyces sp. DBR11, Streptomyces sp. PBR1, and Streptomyces sp. PBR36, were predicted by employing antiSMASH (version 6.0.1) [40]. Nucleotide sequence analysis of all three actinomycetia strains revealed a diverse group of BGCs responsible for the production of bioactive secondary metabolites. They were involved in the biosynthesis of different classes of gene clusters, such as PKSs, NRPS, terpene, lipopeptide, lanthipeptide, siderophore, butyrolactone, NAPAA (nonalpha polyamino group acids), saccharides, and hybrid gene clusters of NRPS-PKS and Terpene + PKS. Nucleotide sequence analysis of Streptomyces sp. DBR11 revealed 31 smBGCs responsible for secondary metabolite production, out of which 24 are related to known types of smBGCs, such as antibiotics, bioactive compounds, and other products. Eight smBGCs were associated with the synthesis of known antibiotics: carbapenem MM4550, albaflavenone, borrelidin, hormaomycin A1-A6, niphimycins C-E, enduracidin, stenothricin, and icosalide A. Ten smBGCs displayed 100% homology to known secondary metabolites: albaflavenone, icosalide A, ashimides, ectoine, rhizomide A-C, isorenieratene, coelibactin, germicidin, sapB, and hopene. Four smBGCs revealed high to moderate homology (50–85% of genes showed similarity) to known gene clusters of undecylprodigiosin, desferrioxamin B/desferrioxamine E, melanin, and spore pigment. Ten BGCs exhibited low homology (<30% of genes showed similarity), and six other BGCs showed no homology to any known secondary metabolites.
Streptomyces sp. PBR1 contains 33 BGCs in its genome, 26 of which were involved in the biosynthesis of known secondary metabolites. Among them, 12 gene clusters were annotated to known antibiotics, such as lankamycin, streptovaricin, lankacidin C, stenothricin, chaxamycin A-D, glycinocin A, albaflavenone, murayaquinone, granaticin, ficellomycin, aurantimycin A, merochlorin A-D/deschloro-merochlorin, and A–B/isochloro-merochlorin B/dichloro-merochlorin B. Moreover, 11 antibiotics were associated with PKS/NRPS pathways, whereas 2 of them were annotated by hybrid (NRP+ Polyketide) and 1 by (Terpene + Polyketide: Type III) gene clusters. Four smBGCs displayed 100% homology to the known gene clusters of albaflavenone, ectoine, and keywimysin, and 2-methylisoborneol and 8 smBGCs represented high to moderate homology (50–85% of genes showed homology) with the known gene clusters of lankamycin, streptovaricin, albaflavenone, desferrioxamin B/desferrioxamine E, 4-Z-annimycin, 4-hexadecanoyl-3-hydroxy-2-(hydroxymethyl)-2H-furan-5-one, flaviolin, and hopene. Fifteen BGCs represented low homology (<40% of genes showed similarity) and six gene clusters showed no homology to any known secondary metabolites.
Streptomyces sp. PBR36 contained 29 smBGCs, 26 of which are known to be associated with secondary metabolites. Significantly, 11 gene clusters encode known antibiotics, albaflavenone, stenothricin, actinomycin D, abyssomicin C, ulleungmycin, streptovaricin, griseoviridin, tylactone, aurantimycin A, and istamycin, where two of them were annotated by hybrid (NRP+ Polyketide and NRP: Cyclic depsipeptide + Polyketide: Trans-AT type I) gene clusters. Six smBGCs revealed 100% similarity to some secondary metabolites, such as albaflavenone, ectoine, sapB, hopene, germicidin, and isorenieratene. Four smBGCs displayed moderate to high homology (60–90% of genes showed homology) to the known gene clusters of actinomycin D, desferrioxamin B, desferrioxamine E, spore pigment, and coelichelin. In total, 16 BGCs revealed low homology (<42% of genes showed similarity), and 3 BGCs showed no homology to any known secondary metabolites.
The presence of highly similar gene clusters in all the three actinomycetia strains suggested they have tremendous potential to generate these secondary metabolites. Interestingly, most of the gene clusters had low (<50%) or no similarity to other known smBGCs, suggesting that the three strains could be a source of novel antibiotics. Complete genome mining results are shown in Figure 8, Table 3A–C.

Figure 8.
Genome mining for identifying smBGCs: (A) Distribution of antiSMASH hits of major classes of smBGCs identified in the genome of three actinomycetia strains; Streptomyces sp. DBR11, Streptomyces sp. PBR1, and Streptomyces sp. PBR36. The clusters of the “Hybrid” type that were predicted to belong to more than one type of BGCs were combined. BGCs predicted to belong to the hopene, ectoine, germicidin, sapB, melanin, geosmin, spore pigment keywimysin, carotenoid, 2-methylisoborneol, or flaviolin types were grouped under “Other”. (B) Comparison of the number and types of secondary metabolites found in the genomes of the three actinomycetia strains. (C) Similarity percentage of BGCs identified in the genome of three actinomycetia strains to known homologous gene clusters. No homology shown by the gene clusters revealed no similarity shared by the BGCs to known gene clusters.
Table 3.
(A) Overview of the predicted secondary metabolites from BGCs of Streptomyces sp. PBR1 by antiSMASH: (B) Overview of the predicted secondary metabolites from BGCs of Streptomyces sp. PBR36 by antiSMASH. (C) Overview of the predicted secondary metabolites from BGCs of Streptomyces sp. DBR11 by antiSMASH.
According to the RAST annotation of the draft genomes of all three actinomycetia strains, PBR36, PBR1, and DBR11 contain the highest number of coding sequences (391, 527, and 370 counts, respectively) for the subsystem of amino acids and derivatives, followed by the subsystem of carbohydrates (333, 459, and 325 counts, respectively) and protein metabolism (222, 209, and 232 counts, respectively). No virulence or toxin-encoding genes were found in the genomes of the three strains. Fluoroquinolone-resistant genes were found in conserved domains of all three actinomycetia strains, whereas genes encoding beta-lactamase resistance were found only in Streptomyces sp. PBR1 strain (Figure 9)

Figure 9.
An overview of the subsystem category of the annotated whole genomes of three actinomycetia strains showing virulence or antibiotic resistance encoding genes using RAST pipeline: (A) Streptomyces sp. PBR36. (B) Streptomyces sp. PBR36. (C) Streptomyces sp. DBR11. Green color in the color bar represents features that are found in the RAST subsystem. The blue color represents features not assigned to a subsystem.
4. Discussion
AMR is a major public health concern, particularly for common bacterial infections such as UTIs, sepsis, sexually transmitted infections, and some forms of diarrhea [58]. Furthermore, the development of new antibiotics has slowed down significantly in recent decades, leading to a limited pipeline of effective drugs to combat resistant bacterial pathogens.
In the present study, the potential of forest-derived actinomycetia was investigated against MDR pathogens. A total of 19 pathogens were isolated from the urine samples obtained from infected patients. The findings showed that Escherichia coli (42%) was the most frequently occurring pathogen in the urine samples, followed by Enterococcus faecalis (32%), Klebsiella pneumoniae (11%), Candida albicans (11%), and Pseudomonas aeruginosa (5%). In vitro antibiotic sensitivity study was performed to investigate the susceptibility of the pathogens to eight different standard antibiotics. The study indicates that only 11% of the pathogens were sensitive to both ciprofloxacin (5 µg) and nalidixic acid (30 µg), while 16% of the pathogens were sensitive to ampicillin (10 µg). This suggests that the tested pathogens are resistant to these antibiotics. Moreover, 21% of the pathogens were sensitive to levofloxacin (5 µg), while co-trimoxazole (25 µg) and norfloxacin (10 µg) were effective against 32% and 31% of the pathogens, respectively. According to a recent systematic review analysis, Gram-negative bacteria have high resistance rates to co-trimoxazole in certain countries in the Asia-Pacific region: India (64–74%), Bangladesh (58%), and Bhutan (53%) [59]. Drugs like ciprofloxacin, which belong to the class of antibiotics known as fluoroquinolones, were once commonly prescribed for UTIs. However, physicians are now more cautious in prescribing ciprofloxacin in areas where the resistance rates are high. A previous study also demonstrated that ciprofloxacin (500 mg) is recommended twice daily for 10–14 days for only mild UTIs [60]. In comparison with the antibiotics listed above, cefazolin (30 g) 36.84% and nitrofurantoin (300 g) 36.84% may be better drug options, because they were effective against pathogens and also showed a clear zone in the antibiotic sensitivity test. According to Antibiotic Research, UK [61] and UNEP (United Nations Environment Program) [62], AMR is a global health concern, and currently, it causes approximately 700,000 deaths annually worldwide. If appropriate measures are not taken to address the issue, it is projected that the annual death toll could reach a staggering 10 million by 2050. Based on in vitro antibiotic susceptibility assay, seven MDR pathogens were isolated from the urine sample of infected patients. Three bacterial pathogens, viz. GNR7 (Enterococcus faecalis), GNR18 (Pseudomonas aeruginosa), and GNR19 (Escherichia coli), were considered to be potent MDR pathogens, because they were resistant to all of the antibiotics used in the antibiotic susceptibility test. They were therefore considered as test pathogens for further in vitro bioassay against isolated actinomycetia strains.
The plant rhizosphere is a hotspot for microbial interactions and activities and is widely being studied by scientists [63,64]. Actinomycetia are important soil microbes that dominate the rhizosphere and contribute to various ecological processes. However, despite their significance, only a small portion actinomycetia has been studied [65]. Assam, located in one of the world’s mega-biodiversity hotspots, is indeed home to diverse forest ecosystems that are considered poorly explored [7]. These forests of Assam harbor a wide range of microbial communities and are recognized as important resources of actinomycetia [7,66]. In the present study, a total of 65 morphologically diverse actinomycetia were isolated from two less explored forest ecosystems of Assam, namely PWS and DBWS. The morphological characterization of the 65 actinomycete isolates was assessed by analyzing various visible morphological characteristics. These characteristics included colony morphology, aerial and substrate mycelium color, and the presence of diffusible pigments. Thirteen isolates of Streptomyces produced a diffusible pigment, which is considered a key feature for the morphological characterization of the Streptomyces [67]. In addition to pigment production, other characteristics such as spore chain length, hyphae structure, and fragmentation of mycelium are also considered for the classification of actinomycetia [68]. The SEM analysis revealed that the aerial mycelia of Streptomyces sp. DBR11, Streptomyces sp. PBR1, and Streptomyces sp. PBR36 are long, straight, and branched with chains of conidiospores. The mycelium of all three actinomycetia is closed, compact, and rectiflexibiles type (Figure 3B).
Actinomycetia are considered one of the most prolific sources of bioactive compounds, and their metabolites have been extensively studied for their potential applications in medicine [21,69]. The present study investigated 65 actinomycetia isolates, and among them, 19 were identified as potent actinomycetia with significant antimicrobial activity on Gram-positive bacteria, Gram-negative bacteria, Candida species, and 3 MDR pathogens. During the screening of actinomycetia isolates for antagonistic activity, seven isolates exhibited broad-spectrum activity against all the pathogens, and three strains, viz. Streptomyces sp. PBR1, Streptomyces sp. PBR36, and Streptomyces sp. DBR11, exhibited broad-spectrum activity with a significantly larger zone of inhibition compared with the other isolates. Both PBR1 and PBR36 were isolated from soil samples of PWS, while DBR11 was isolated from DBWS. Similarly, in our recent work with Streptomyces sp. PBR11 isolated from a forest ecosystem, we observed similar broad-spectrum antimicrobial activity and characterized the presence of an antituberculosis drug ethambutol. In addition, the study demonstrated antimicrobial activity of its bioactive fraction against 19 test pathogens, including MDR clinical pathogens and dermatophytes [7]. Likewise, the present study also suggests that forest ecosystems are an excellent resource of many actinomycetia exhibiting antagonistic activity against different drug-resistant pathogens. Currently, no studies have been published on the investigation of the antimicrobial activity of actinomycetia from the ecosystem of DBWS of Assam. As a Ramsar site on the southwest outskirts of Guwahati, Assam, DBWS merits special attention for the investigation of novel actinomycetia with therapeutic applications. A Ramsar site is a wetland area that has been given international significance under the Ramsar Convention, also known as “The Convention on Wetlands”, an international environmental agreement that was established on February 2nd, 1971, in Ramsar, Iran by UNESCO [70]. This is the first report on the scientific evidence of actinomycetia from DBWS that demonstrated broad-spectrum activity against MDR clinical pathogens.
Crude ethyl acetate extracts of three actinomycetia strains, Streptomyces sp. PBR1, Streptomyces sp. PBR36, and Streptomyces sp. DBR11, were selected for MIC studies based on their antimicrobial potential against the MDR pathogens. Streptomyces sp. PBR1 exhibited the lowest MIC against MRSA (0.195 µg/mL). Streptomyces sp. PBR36 exhibited the lowest MIC against Candida albicans (0.097 µg/mL) and exhibited an MIC of 0.781 µg/mL against both MDR Escherichia coli (clinical isolate, GNR19) and MRSA. Streptomyces sp. DBR11 exhibited the lowest MIC against Candida albicans (0.195 µg/mL). Recently, similar findings were reported, where EA-Kz-24 exhibited the lowest MIC against MRSA ATCC 43,300 and Candida albicans MTCC 227 (0.024 µg/mL) [48]. Notably, the MIC values showed by the crude extract of the three potent stains were significantly lower than those of the standard antimicrobial drugs. This is the first report where the actinomycetia isolates showed broad-spectrum activity against MDR pathogens at the lowest MIC values. Furthermore, SEM analysis revealed remarkable morphological and physiological changes, such as cell shrinkage and ruptured cell walls in the treated cells of Candida albicans MTCC 227 and Escherichia coli GNR19. This suggests that the antimicrobial action of EtAc-PBR36 against pathogens is mediated by a membrane disruption mechanism that inhibits further cell growth.
16S rRNA gene sequencing has been widely used as an effective molecular technique for genus-level classification of bacteria [71]. Nineteen antagonistic actinomycetia isolates were partially identified by 16S rRNA gene sequencing. Nucleotide sequences of the isolates showed 92–100% similarity with the reference sequence in the EzTaxon database. Two strains, Streptomyces sp. PBR11 (92.91%) and Streptomyces sp. PBR19 (93.96%), presented very low sequence similarities to their nearest type strain and formed a distinct subclade from the other members of actinomycetia strains, which suggested that these two strains can be considered under the novel taxa. The three most potent actinomycetia strains, PBR1, PBR36, and DBR11, were identified as Streptomyces sp. Based on the similarity search of 16S rRNA gene sequences. However, upon taxonomic identification by ANI method [39] from WGS, the isolates were identified as Streptomyces coelicoflavus, Streptomyces longispororuber, and Streptomyces parvulus, respectively, with high confidence levels. Phylogenetic analysis by 16s rRNA gene sequences revealed two major clusters, the first cluster mainly comprises Streptomyces species, and in the other, rare actinomycetia such as Nocardia, Nonomuraea, and Actinomadura. The genetic diversity in the present study suggests that the soil of protected forest ecosystems of Assam is a rich source of Streptomyces, indicating that these forest areas could be a storehouse of many novel and rare actinomycetia with therapeutic potentials.
The metabolic gene clusters PKS-II and NRPS play key roles in the biosynthesis of bioactive secondary metabolites, which are responsible for the production of therapeutically relevant natural products, such as antibiotic, antifungal, antiviral, antitumor, and anticancer compounds [72]. Out of the 19 potent actinomycetia strains, 17 strains (89.47%) of actinomycetia exhibited positive results for PKS-II gene, whereas the NRPS gene was detected in 6 actinomycetia strains (31.57%). Both biosynthetic genes, PKS-II and NRPS, were detected in six strains viz. Streptomyces sp. PBR30, Streptomyces sp. PBR35, Nocardia sp. DBRX, Streptomyces sp. PBR1, Streptomyces sp. PBR36, and Streptomyces sp. DBR11. Notably, most of the potent strains, especially Streptomyces sp., were found to contain PKS-II genes, which might be responsible for their involvement in the biosynthesis of antimicrobial secondary metabolites. These findings also corroborate the previous studies conducted by other researchers [21,73]. The lack of amplification of PKS-II and NRPS gene sequences in some of the potent actinomycetia strains may be due to the absence of these specific biosynthetic genes in their genome, and secondary metabolites may be produced through some other biosynthetic pathways [21].
GC-MS is an effective analytical tool that is often used to identify metabolites from different sources by their MS fingerprint [74,75]. Several research articles have been published on GC-MS-based research for natural product chemistry and drug discovery [7,21]. In the present study, solvent extracts from three actinomycetia strains, Streptomyces sp. PBR1, Streptomyces sp. PBR36, and Streptomyces sp. DBR11, were subjected to GC-MS analysis to study the bioactive compounds produced by them. A total of nineteen major chemical compounds were detected based on their retention time and abundance, of which twelve are known to exhibit biological activities. For instance, isonipecotic acid, N-(3-fluoro-5-trifluoromethylbenzoyl)-, and eicosyl ester detected in the ethyl acetate extract of Streptomyces sp. PBR1 have potential anticonvulsant properties [42]. 4-bromo-2-trifluoromethylphenyl isothiocyanate exhibited antiviral activity against Zika virus [43]. An organofluoride compound, haloperidol TMS derivative, acts as a novel potent calcium channel blocker with vasodilator activity [44]. Moreover, three other compounds detected in the ethyl acetate extract of PBR1 strain, viz. Spiro [5.5] undecane, 1-methylene, 9-acridanone, 9-Acridanone, 1-ethoxy-3-methoxy- 10-methyl, and fluoxymesterone detected in the ethyl acetate extract of PBR1 strain, exhibited antimicrobial, antiviral, antimalarial, anti-inflammatory, and antianemia activities [45,46,47,48,49]. Similarly, in Streptomyces sp. PBR36, four bioactive compounds, resibufogenin, o-veratramide, 5-dicyanomethylene-9-diethylamino-6-fluorobenzo[a] phenoxazine, and lanostan-3. β. -ol, 11. beta,19-epoxy, have been identified to have anticancer, antimicrobial, antitumor, antimalaria, anti-M. tuberculosis, and anti-inflammation activities, respectively. The results are also found to be in agreement with previous studies [50,51,52,53,54,55]. Two compounds, L-cysteine, N-acetyl-, methyl ester, acetate, and desflurane, detected in Streptomyces sp. DBR11, exhibited mucolytic, antioxidant [76], and anesthetic activity [57], respectively. However, reports on the biological activities of compounds, such as 5-amino-6-methoxy-8-nitroquinoline, acetic acid, hydrazino-, ethyl ester, 1-anthracenyl-2-pyridyl ketone, 2-(4-bromo-phenyl)-indolizine, 2-Bromo-N- (4-bromo-2-(2, bromo-benzoyl)-phenyl)-acetamide, D: A-friedooleanan-3-ol, (3. α), and cyclopentanecarboxylic ac-id,1-(4-ethoxy-4-oxo-2-butenyl)-2-oxo-, ethyl ester, have not been published.
Genome mining is becoming a popular approach for accelerating the identification and characterization of the diverse classes of smBGCs [76,77]. The genome mining of the three most potent actinomycetia strains, Streptomyces sp. DBR11, Streptomyces sp. PBR1, and Streptomyces sp. PBR36 has revealed the presence of approximately 29–33 BGCs associated with the biosynthesis of PKSs (type I, II, and III PKSs), NRPSs, terpene, lipopeptide, lanthipeptide, siderophore and butyrolactone, NAPAA (nonalpha polyamino group acids), saccharides, and other natural products. The presence of such a diverse array of BGCs indicates that all three strains have the potential to produce a wide range of secondary metabolites. Lanthipeptides, like PKSs and NRPSs, are also biologically significant chemical classes involved in the production of antimicrobial drugs. For example, cadasides, malacidins, and teixobactin are all peptide antibiotics that have been reported in recent years for their promising antimicrobial activity against various MDR bacterial pathogens [78,79,80,81]. Streptomyces sp. DBR11 and Streptomyces sp. PBR36 were found to have lanthipeptide class-I gene clusters, while the PBR1 strain had lanthipeptide class-II gene clusters. Also, most of the BGCs identified in these three strains are assigned to the polyketide domain, followed by NRPS and terpene biosynthesis, while in the genome of Streptomyces sp. DBR11, most of the BGCs encode the biosynthesis of NRPS, followed by PKSs, lanthipeptides, and terpenes. One of the key findings of this study is that actinomycetia strains isolated from the same area have similar sets of BGCs. This similarity suggests that these strains may have acquired the genes responsible for the biosynthesis of these secondary metabolites through horizontal gene transfer (HGT) [82]. Furthermore, antiSMASH analysis of three actinomycetia strain genomes revealed that the predicted gene clusters in these strains have no significant similarity or homology with known secondary metabolites. The lack of similarity suggests that the bioactive metabolites produced by these strains might be novel. Researchers are particularly interested in hybrid systems of BGCs, because high levels of secondary metabolites can be derived from a combination of NRPS and PKS gene clusters, resulting in a wide range of structures and diverse chemical compounds with high therapeutic potential [83]. Remarkably, all three Streptomyces strains carried NRPS-PKS and Terpene + PKS hybrid gene clusters.
It has previously been established that strains of the same bacterial species frequently encode a core set of BGCs, but they can also encode some additional clusters that differ significantly between strains [84]. Streptomyces sp. PBR1 and Streptomyces sp. PBR36 both contain smBGC, which codes for streptovaricin, a macrolide antibiotic with exceptional antimicrobial activity against MRSA and Mycobacterium tuberculosis [85]. Likewise, the strains also carried a gene cluster for aurantimycin A, a depsipeptide antibiotic with potent antitumor and antimicrobial activity [86]. BGCs coding for stenothricin, a nonribosomal peptide-derived antibiotic, and albaflavenone, a sesquiterpene antibiotic, was found in the genomes of all three actinomycetia stains. Stenothricin exhibited strong antibacterial activity [87], and albaflavenone has shown cytotoxic activity [88]. Moreover, other gene clusters which were detected in Streptomyces sp. PBR1 were responsible for production of lankamycin [89], lankacidin C [90], chaxamycin A-C [91], glycinocin A [92], murayaquinone [93], ficellomycin [94], and merochlorin A [95]. All of these smBGCs demonstrated significant antimicrobial activity. Gene clusters for other secondary metabolites like granaticin and violapyrone B were also detected in the genome of PBR1 stain. Granaticin is known to exhibit antibacterial and anticancer activities [96], and violapyrone B showed antibacterial, antitumor [97], and anti-influenza A (H1N1) activity [98].
Similarly, Streptomyces sp. PBR36 contains smBGCs that encode for ulleungmycin [99], griseoviridin [100], tylactone [101], and istamycin [102], all of which have antimicrobial activity against MDR bacterial pathogens. PBR36 also encodes the biosynthesis of abyssomicin C and actinomycin D gene clusters. Abyssomicin C is evidenced to possess significant antibacterial activity against Gram-positive bacteria, including MDR and vancomycin-resistant bacterial strains [103]. Likewise, actinomycin D is a well-known antibiotic used to treat various cancers [104,105]. Streptomyces sp. DBR11 contains smBGCs, which encode carbapenem MM4550 [106], borrelidin [107], hormaomycin A1-A6 [108], niphimycins C-E [109], enduracidin [110,111], and icosalide A [112] antibiotics with potent antimicrobial activity against various bacterial pathogens including MDR pathogens.
Gene clusters for bioactive compounds, such as desferrioxamin B/desferrioxamine E, foxicin A, polyoxypeptin, ashimides, herboxidiene, undecylprodigiosin, and chejuenolide A-B, were detected in the three potent actinomycetia strains. Desferrioxamine, as an iron-chelating molecule, is frequently used in clinical conditions to treat iron overload and for the treatment of hereditary hemochromatosis and thalassemia [113]. Similarly, foxicin showed moderate antibiotic activity in a recent study [114]. Polyoxypeptin is a potent apoptosis inducer [115], ashimides showed cytotoxic activity [116], herboxidiene is a potent antitumor agent [117], undecylprodigiosin is reported to exhibit antimicrobial, anticancer, and antimalarial activities [118], and chejuenolide A-B exhibited antimicrobial activity [119]. The synthesis of these bioactive secondary metabolites may be responsible for the broad-spectrum antimicrobial activity of the three potent actinomycetia strains against MDR pathogens.
Many clinically significant antibiotics are produced by actinomycetia, particularly from the genus Streptomyces. BGCs often contain genes that offer resistance to the antibiotics they produce. These antibiotic-resistant genes play a vital role in the self-defense mechanism against their own antibiotics. Without such resistance mechanisms, the actinomycetia would be susceptible to self-toxicity caused by the synthesized antibiotics [120]. Antibiotic-resistance-guided screening is another novel method for discovering antibacterial compounds. Previously, this method was used to boost the production of aminoglycosides and lincosamides [121,122]. One research team used the resistance-based screening approach to find ansamycins using rifamycin resistance. Their study discovered high hit rates from glycopeptide antibacterials screening and identified several ansamycin producers [123]. RAST based evaluation of the whole-genome-sequenced actinomycetia strains revealed that the strains PBR1, PBR36, and DBR11 carried genes encoding fluroquinolone resistance. Additionally, the beta-lactam-resistant genes were present in the conserved regions of the genome of the Streptomyces sp. PBR1 strain.
5. Conclusions
In this work, both the genome mining and GC-MS analysis of all three actinomycetia strains, namely Streptomyces sp. DBR11, Streptomyces sp. PBR1, and Streptomyces sp. PBR36, revealed a diverse group of biologically active chemical classes with therapeutic potential, respectively. GC-MS analysis revealed that all three potent strains displayed diverse groups of chemical compounds, like heterocyclic compounds, phenyl, steroid, glycosides, amides, and ketones. These are often referred to as therapeutically important chemical classes, responsible for significant antimicrobial, antitumor, antimalaria, antituberculosis, anticancer, and anti-inflammatory activities. Similarly, the WGS data of the three potent strains also revealed that they contain a diverse group of BGCs associated with the biosynthesis of biologically important secondary metabolites with high therapeutic applications. In addition, the low MIC values and the SEM analysis of the pathogen’s cell surface morphology after treatment with the extract from three strains indicated that they may be promising antimicrobial candidates against drug-resistant human pathogens. The results of this study further support the significance of these forest-derived actinomycetia strains for future drug discovery. Overall, the findings emphasize the need for a comprehensive examination of the secondary metabolites produced by Streptomyces, as this could potentially lead to the discovery of novel pharmaceutical compounds.
Supplementary Materials
The following supporting information can be downloaded at https://www.mdpi.com/article/10.3390/metabo13080911/s1, Figure S1: GC-MS analysis of the ethyl acetate extracts of actinomycetia strains: Chemical structures of the identified compounds (I) Streptomyces sp. PBR1; (II) Streptomyces sp. PBR36; and (III) Streptomyces sp. DBR11; Table S1: In vitro sensitivity profile of MDR pathogens against standard antibiotics; Table S2: Morphological characteristics of 65 actinomycetia isolates with their respective media and place of isolation; Table S3: Presence of biosynthetic genes (PKS II and NRPS) and antimicrobial activity of the representative isolates of actinomycetia; Table S4: Antimicrobial activity of actinomycetia isolates by well diffusion method against MDR pathogens; Table S5: Molecular identification of antagonistic actinomycetia based on 16S rRNA gene sequences; Table S6: WGS assembly statistics, quality report, and taxonomic identification of Streptomyces sp. DBR11, Streptomyces sp. PBR1, and Streptomyces sp. PBR36.
Author Contributions
Conceptualization, R.M. and D.T.; methodology, R.M. and D.T.; software, K.S.; validation, R.M. and D.T.; formal analysis, R.M.; investigation, R.M.; resources, R.M. and D.T.; data curation, R.M.; writing—original draft preparation, R.M.; writing—review and editing, R.M. and D.T.; visualization, R.M.; supervision, D.T.; project administration, D.T.; funding acquisition, D.T. All authors have read and agreed to the published version of the manuscript.
Funding
This work was partially supported by the IASST core fund project (Grant No. IASST/R&D/LSD/IHP-06/2023-24/1284-1289).
Institutional Review Board Statement
Not applicable.
Informed Consent Statement
Not applicable.
Data Availability Statement
The data presented in this study are available in the main text and supplementary Table S5.
Acknowledgments
The authors are grateful to the Director of the Institute of Advanced Study in Science and Technology (IASST), Assam, India for providing facilities for this work. The authors are thankful to BIF (Bioinformatics Facility) and SAIC (Sophisticated Analytical Instrument Centre), IASST, for their assistance.
Conflicts of Interest
The authors declare no conflict of interest. The funders had no role in the design of the study; in the collection, analyses, or interpretation of data; in the writing of the manuscript; or in the decision to publish the results.
References
- Miller, W.R.; Munita, J.M.; Arias, C.A. Mechanisms of antibiotic resistance in enterococci. Expert Rev. Anti-Infect. Ther. 2014, 12, 1221–1236. [Google Scholar] [CrossRef]
- De Simeis, D.; Serra, S. Actinomycetes: A never-ending source of bioactive compounds—An overview on antibiotics production. Antibiotics 2021, 10, 483. [Google Scholar] [CrossRef]
- Temkin, E.; Fallach, N.; Almagor, J.; Gladstone, B.P.; Tacconelli, E.; Carmeli, Y. Estimating the number of infections caused by antibiotic-resistant Escherichia coli and Klebsiella pneumoniae in 2014: A modelling study. Lancet Glob. Health. 2018, 6, e969–e979. [Google Scholar] [CrossRef]
- Akinyemi, K.O.; Abegunrin, R.O.; Iwalokun, B.A.; Fakorede, C.O.; Makarewicz, O.; Neubauer, H.; Wareth, G. The Emergence of Klebsiella pneumoniae with reduced susceptibility against third generation cephalosporins and carbapenems in Lagos Hospitals, Nigeria. Antibiotics 2021, 10, 142. [Google Scholar] [CrossRef] [PubMed]
- World Health Organization. Antimicrobial Resistance. Available online: https://www.who.int/news-room/fact-sheets/detail/antimicrobial-resistance (accessed on 22 February 2022).
- Mazumdar, R.; Thakur, D. Therapeutic Applications of Nanotechnology in the Prevention of Infectious Diseases. In Emerging Nanomaterials for Advanced Technologies; Springer International Publishing: Cham, Switzerland, 2022; pp. 323–343. [Google Scholar] [CrossRef]
- Mazumdar, R.; Dutta, P.P.; Saikia, J.; Borah, J.C.; Thakur, D. Streptomyces sp. Strain PBR11, a Forest-Derived Soil Actinomycetia with Antimicrobial Potential. Microbiol. Spectr. 2023, 11, e0348922. [Google Scholar] [CrossRef] [PubMed]
- Hazarika, S.N.; Thakur, D. Actinobacteria. In Beneficial Microbes in Agro-Ecology; Academic Press: Cambridge, MA, USA, 2020; pp. 443–476. [Google Scholar] [CrossRef]
- Donald, L.; Pipite, A.; Subramani, R.; Owen, J.; Keyzers, R.A.; Taufa, T. Streptomyces: Still the biggest producer of new natural secondary metabolites, a current perspective. Microbiol. Res. 2022, 13, 418–465. [Google Scholar] [CrossRef]
- Medema, M.H.; Trefzer, A.; Kovalchuk, A.; Van Den Berg, M.; Müller, U.; Heijne, W.; Wu, L.; Alam, M.T.; Ronning, C.M.; Nierman, W.C.; et al. The sequence of a 1.8-Mb bacterial linear plasmid reveals a rich evolutionary reservoir of secondary metabolic pathways. Genome Biol. Evol. 2010, 2, 212–224. [Google Scholar] [CrossRef]
- Hu, D.; Sun, C.; Jin, T.; Fan, G.; Mok, K.M.; Li, K.; Lee, S.M.Y. Exploring the potential of antibiotic production from rare actinobacteria by whole-genome sequencing and guided MS/MS analysis. Front. Microbiol. 2020, 11, 1540. [Google Scholar] [CrossRef] [PubMed]
- Newman, D.J.; Cragg, G.M. Natural products as sources of new drugs over the nearly four decades from 01/1981 to 09/2019. J. Nat. Prod. 2020, 83, 770–803. [Google Scholar] [CrossRef]
- Atanasov, A.G.; Zotchev, S.B.; Dirsch, V.M.; Supuran, C.T. Natural products in drug discovery: Advances and opportunities. Nat. Rev. Drug Discov. 2021, 20, 200–216. [Google Scholar] [CrossRef]
- Singh, B.P.; Rateb, M.E.; Rodriguez-Couto, S.; Polizeli, M.D.L.T.D.M.; Li, W.J. Microbial secondary metabolites: Recent developments and technological challenges. Front. Microbiol. 2019, 10, 914. [Google Scholar] [CrossRef] [PubMed]
- Zhang, X.Y.; Han, X.X.; Chen, X.L.; Dang, H.Y.; Xie, B.B.; Qin, Q.L.; Zhang, Y.Z. Diversity of cultivable protease-producing bacteria in sediments of Jiaozhou Bay, China. Front. Microbiol. 2019, 10, 1404. [Google Scholar] [CrossRef] [PubMed]
- Saravanan, D.; Bharathi, S.; Radhakrishnan, M.; Balagurunathan, R. Exploitation of bacteria from forest ecosystem for antimicrobial compounds. Appl. Pharm. Sci. 2012, 30, 120–123. [Google Scholar] [CrossRef]
- Lladó, S.; López-Mondéjar, R.; Baldrian, P. Forest soil bacteria: Diversity, involvement in ecosystem processes, and response to global change. Microbiol. Mol. Biol. Rev. 2017, 81, e00063-16. [Google Scholar] [CrossRef]
- Jiang, Y.; Li, Q.; Chen, X.; Jiang, C. Isolation and cultivation methods of Actinobacteria. In Actinobacteria-Basics and Biotechnological Applications; Intechopen: London, UK, 2016; pp. 39–57. [Google Scholar] [CrossRef]
- Jiang, Y.; Cao, Y.R.; Wiese, J.; Lou, K.; Zhao, L.X.; Imhoff, J.F.; Jiang, C.L. A new approach of research and development on pharmaceuticls from actinomycetes. J. Life Sci. 2009, 3, 52–56. [Google Scholar]
- Hug, J.J.; Bader, C.D.; Remškar, M.; Cirnski, K.; Müller, R. Concepts and methods to access novel antibiotics from actinomycetes. Antibiotics 2018, 7, 44. [Google Scholar] [CrossRef]
- Sharma, P.; Thakur, D. Antimicrobial biosynthetic potential and diversity of culturable soil actinobacteria from forest ecosystems of Northeast India. Sci. Rep. 2020, 10, 4104. [Google Scholar] [CrossRef] [PubMed]
- Schneider, Y.K. Bacterial natural product drug discovery for new antibiotics: Strategies for tackling the problem of antibiotic resistance by efficient bioprospecting. Antibiotics 2021, 10, 842. [Google Scholar] [CrossRef]
- Available online: https://www.studocu.com/in/document/university-of-kerala/tourism-society/the-biodiversity-of-assam/26012545 (accessed on 21 April 2023).
- Pezzlo, M. Detection of urinary tract infections by rapid methods. Clin. Microbiol. Rev. 1988, 1, 268–280. [Google Scholar] [CrossRef]
- CLSI. Performance Standards for Antimicrobial Susceptibility Testing, 30th ed.; CLSI supplement M100; Clinical and Laboratory Standards Institute: Wayne, PA, USA, 2020. [Google Scholar]
- Kumar, V.; Bharti, A.; Gusain, O.; Bisht, G.S. Scanning electron microscopy of Streptomyces without use of any chemical fixatives. Scanning 2011, 33, 446–449. [Google Scholar] [CrossRef] [PubMed]
- Grammer, A. Antibiotic sensitivity and Assay test. In Microbiological Methods; Collins, C.H., Lyne, P.M., Eds.; Butterworths Co. Ltd.: London, UK, 1976. [Google Scholar]
- Wu, H.; Zhang, Z.; Hu, S.; Yu, J. On the molecular mechanism of GC content variation among eubacterial genomes. J. Bacteriol. 1991, 173, 697–703. [Google Scholar] [CrossRef] [PubMed]
- Altschul, S.F.; Gish, W.; Miller, W.; Myers, E.W.; Lipman, D.J. Basic local alignment search tool. J. Mol. Biol. 1990, 215, 403–410. [Google Scholar] [CrossRef]
- Kumar, S.; Stecher, G.; Tamura, K. MEGA X: Molecular Evolutionary Genetics Analysis across Computing Platforms. Mol. Biol. Evol. 2018, 33, 1870–1874. [Google Scholar] [CrossRef]
- Felsenstein, J. Confidence limits on phylogenies: An approach using the bootstrap. Evolution 1985, 39, 783–791. [Google Scholar] [CrossRef]
- Ayuso-Sacido, A.; Genilloud, O. New PCR primers for the screening of NRPS and PKS-I systems in actinomycetes: Detection and distribution of these biosynthetic gene sequences in major taxonomic groups. Microb. Ecol. 2005, 49, 10–24. [Google Scholar] [CrossRef]
- Bolger, A.M.; Lohse, M.; Usadel, B. Trimmomatic: A flexible trimmer for Illumina sequence data. Bioinformatics 2014, 30, 2114–2120. [Google Scholar] [CrossRef]
- Wick, R.R.; Judd, L.M.; Gorrie, C.L.; Holt, K.E. Unicycler: Resolving bacterial genome assemblies from short and long sequencing reads. PLoS Comput. Biol. 2017, 13, e1005595. [Google Scholar] [CrossRef]
- Gurevich, A.; Saveliev, V.; Vyahhi, N.; Tesler, G. QUAST: Quality assessment tool for genome assemblies. Bioinformatics 2013, 29, 1072–1075. [Google Scholar] [CrossRef]
- Manni, M.; Berkeley, M.R.; Seppey, M.; Simão, F.A.; Zdobnov, E.M. BUSCO update: Novel and streamlined workflows along with broader and deeper phylogenetic coverage for scoring of eukaryotic, prokaryotic, and viral genomes. Mol. Biol. Evol. 2021, 38, 4647–4654. [Google Scholar] [CrossRef] [PubMed]
- Simão, F.A.; Waterhouse, R.M.; Ioannidis, P.; Kriventseva, E.V.; Zdobnov, E.M. BUSCO: Assessing genome assembly and annotation completeness with single-copy orthologs. Bioinformatics 2015, 31, 3210–3212. [Google Scholar] [CrossRef]
- Zhao, Y.; Wu, J.; Yang, J.; Sun, S.; Xiao, J.; Yu, J. PGAP: Pan-genomes analysis pipeline. Bioinformatics 2012, 28, 416–418. [Google Scholar] [CrossRef] [PubMed]
- Ciufo, S.; Kannan, S.; Sharma, S.; Badretdin, A.; Clark, K.; Turner, S.; Di Cuccio, M. Using average nucleotide identity to improve taxonomic assignments in prokaryotic genomes at the NCBI. Int. J. Syst. Evol. Microbiol. 2018, 68, 2386. [Google Scholar] [CrossRef] [PubMed]
- Blin, K.; Shaw, S.; Kloosterman, A.M.; Charlop-Powers, Z.; Van Wezel, G.P.; Medema, M.H.; Weber, T. antiSMASH 6.0: Improving cluster detection and comparison capabilities. Nucleic Acids Res. 2021, 49, W29–W35. [Google Scholar] [CrossRef]
- Aziz, R.K.; Bartels, D.; Best, A.A.; DeJongh, M.; Disz, T.; Edwards, R.A.; Formsma, K.; Gerdes, S.; Glass, E.M.; Kubal, M.; et al. The RAST Server: Rapid annotations using subsystems technology. BMC Genom. 2008, 9, 75. [Google Scholar] [CrossRef]
- Crider, A.M.; Tita, T.T.; Wood, J.D.; Hinko, C.N. Esters of nipecotic and isonipecotic acids as potential anticonvulsants. Pharm. Sci. 1982, 71, 1214–1219. [Google Scholar] [CrossRef]
- Khachatoorian, R.; Micewicz, E.D.; Micewicz, A.; French, S.W.; Ruchala, P. Optimization of 1, 3-disubstituted urea-based inhibitors of Zika virus infection. Bioorg. Med. Chem. Lett. 2019, 29, 126626. [Google Scholar] [CrossRef]
- Chen, Y.; Zheng, J.; Zheng, F.; Wang, J.; Zhang, Y.; Gao, F.; Huang, Z.; Shi, G. Design, synthesis, and pharmacological evaluation of haloperidol derivatives as novel potent calcium channel blockers with vasodilator activity. PLoS ONE 2011, 6, e27673. [Google Scholar] [CrossRef]
- Schepens, W.; Van Haver, D.; Vandewalle, M.; De Clercq, P.J.; Bouillon, R.; Verstuyf, A. Synthesis and biological activity of 22-oxa CD-ring modified analogues of 1α, 25-dihydroxyvitamin D3: Spiro [5.5] undecane CF-ring analogues. Bioorg. Med. Chem. Lett. 2004, 14, 3889–3892. [Google Scholar] [CrossRef]
- Yerragunta, V.; Reddy, E.S.; Kishore, M.; Sadia, A.; Saba, A.; Fatima, S. A review on acridone derivatives and its importance. PharmaTutor 2015, 3, 27–29. [Google Scholar]
- Kennedy, B.J. Fluoxymesterone therapy in advanced breast cancer. N. Engl. J. Med. 1958, 259, 673–675. [Google Scholar] [CrossRef]
- Al-Othman, N.; Alhendi, A.; Ihbaisha, M.; Barahmeh, M.; Alqaraleh, M.; Al-Momany, B.Z. Role of CD44 in breast cancer. Breast Dis. 2020, 39, 1–13. [Google Scholar] [CrossRef]
- Niţă, I.; Niţipir, C.; Toma, Ş.A.; Limbău, A.M.; Pîrvu, E.; Bădărău, I.A. The importance of androgen receptors in breast cancer. Med. Pharm. Rep. 2021, 94, 273. [Google Scholar] [CrossRef]
- Lu, Z.; Xu, A.; Yuan, X.; Chen, K.; Wang, L.; Guo, T. Anticancer effect of resibufogenin on gastric carcinoma cells through the phosphoinositide 3 kinase/protein kinase B/glycogen synthase kinase 3β signaling pathway. Oncol. Lett. 2018, 16, 3297–3302. [Google Scholar] [CrossRef]
- Al-Salman, H.N. Isolation and diagnosis of phytochemicals extracted from pomegranate husks and study of the biological effect of extract [O-Veratramide] as an antimicrobial activity. Int. J. Green Pharm. 2018, 12. [Google Scholar] [CrossRef]
- Wesolowska, O.; Molnar, J.; Westman, G.; Samuelsson, K.; Kawase, M.; Ocsovszki, I.; Motohashi, N.; Michalak, K. Benzo [a] phenoxazines: A new group of potent P-glycoprotein inhibitors. In Vivo 2006, 20, 109–113. [Google Scholar]
- Ge, J.F.; Arai, C.; Yang, M.; Bakar, M.d.A.; Lu, J.; Ismail, N.S.; Wittlin, S.; Kaiser, M.; Brun, R.; Charman, S.A.; et al. Discovery of novel benzo [a] phenoxazine SSJ-183 as a drug candidate for malaria. ACS Med. Chem. Lett. 2010, 1, 360–364. [Google Scholar] [CrossRef]
- Tanner, L.; Evans, J.C.; Seldon, R.; Jordaan, A.; Warner, D.F.; Haynes, R.K.; Parkinson, C.J.; Wiesner, L. In vitro efficacies, ADME, and pharmacokinetic properties of phenoxazine derivatives active against Mycobacterium tuberculosis. Antimicrob. Agents Chemother. 2019, 63, e01010–e01019. [Google Scholar] [CrossRef]
- Giner-Larza, E.M.; Máñez, S.; Giner-Pons, R.M.; Recio, M.C.; Ríos, J.L. On the anti-inflammatory and anti-phospholipase A2 activity of extracts from lanostane-rich species. J. Ethnopharmacol. 2000, 73, 61–69. [Google Scholar] [CrossRef]
- Giustarini, D.; Milzani, A.; Dalle-Donne, I.; Tsikas, D.; Rossi, R. N-Acetylcysteine ethyl ester (NACET): A novel lipophilic cell-permeable cysteine derivative with an unusual pharmacokinetic feature and remarkable antioxidant potential. Biochem. Pharmacol. 2012, 84, 1522–1533. [Google Scholar] [CrossRef]
- Varkey, J. Debunking volatile anesthetic cost myths between sevoflurane and desflurane. Anesth. eJ. 2013, 1. [Google Scholar]
- World Health Organization. Report on Antimicrobial Resistance. 2021. Available online: https://www.who.int/news-room/fact-sheets/detail/antimicrobial-resistance (accessed on 17 November 2022).
- Sugianli, A.K.; Ginting, F.; Parwati, I.; de Jong, M.D.; van Leth, F.; Schultsz, C. Antimicrobial resistance among uropathogens in the Asia-Pacific region: A systematic review. JAC Antimicrob. Resist. 2021, 3, dlab003. [Google Scholar] [CrossRef]
- Grabe, M.; Bjerklund-Johansen, T.E.; Botto, H.; Çek, M.; Naber, K.G.; Tenke, P.; Wagenlehner, F. Guidelines on urological infections. Eur. Assoc. Urol. 2023, 182, 237–257. [Google Scholar]
- Available online: https://www.worldbank.org/en/topic/health/brief/antimicrobial-resistance-amr (accessed on 21 April 2021).
- Available online: https://www.unep.org/explore-topics/chemicals-waste/what-we-do/emerging-issues/antimicrobial-resistance-global-threat (accessed on 6 January 2023).
- Choudhary, S.; Singh, A.; Rani, M. Rhizosphere: Hotspot of Soil-Microbes-Plant Interaction; A Monthly Peer Reviewed Magazine for Agriculture and Allied Sciences; Springer: Singapore, 2020; Volume 80. [Google Scholar]
- Hartmann, A.; Schmid, M.; Tuinen, D.V.; Berg, G. Plant-driven selection of microbes. Plant Soil 2009, 321, 235–257. [Google Scholar] [CrossRef]
- Hill, P.; Krištůfek, V.; Dijkhuizen, L.; Boddy, C.; Kroetsch, D.; van Elsas, J.D. Land use intensity controls actinobacterial community structure. Microb. Ecol. 2011, 61, 286–302. [Google Scholar] [CrossRef] [PubMed]
- Thakur, D.; Yadav, A.; Gogoi, B.K.; Bora, T.C. Isolation and screening of Streptomyces in soil of protected forest areas from the states of Assam and Tripura, India, for antimicrobial metabolites. J. Mycol. Med. 2007, 17, 242–249. [Google Scholar] [CrossRef]
- Arai, T.; Mikami, Y. Chromogenicity of Streptomyces. Morphological identification of actinobacteria. Actinobacteria-basics and biotechnological applications. Appl. Microbiol. 2016, 23, 402–406. [Google Scholar] [CrossRef]
- Shivlata, L.; Satyanarayana, T. Thermophilic and alkaliphilic Actinobacteria: Biology and potential applications. Front. Microbiol. 2015, 6, 1014. [Google Scholar] [CrossRef]
- Zahroh, E.W.; Ningsih, F.; Sjamsuridzal, W. Detection of antimicrobial compounds from thermophilic actinomycetes using one strain many compounds [OSMAC] approach. Biolink 2022, 9, 76–94. [Google Scholar] [CrossRef]
- Kingsford, R.T.; Bino, G.; Finlayson, C.M.; Falster, D.; Fitzsimons, J.A.; Gawlik, D.E.; Thomas, R.F. Ramsar wetlands of international importance–improving conservation outcomes. Front. Environ. Sci. 2021, 9, 643367. [Google Scholar] [CrossRef]
- Cook, A.E.; Meyers, P.R. Rapid identification of filamentous actinomycetes to the genus level using genus-specific 16S rRNA gene restriction fragment patterns. Int. J. Syst. Evol. Microbiol. 2003, 53, 1907–1915. [Google Scholar] [CrossRef]
- Rutledge, P.J.; Challis, G.L. Discovery of microbial natural products by activation of silent biosynthetic gene clusters. Nat. Rev. Microbiol. 2015, 13, 509–523. [Google Scholar] [CrossRef] [PubMed]
- Lee, L.H.; Zainal, N.; Azman, A.S.; Eng, S.K.; Goh, B.H.; Yin, W.F.; Chan, K.G. Diversity and antimicrobial activities of actinobacteria isolated from tropical mangrove sediments in Malaysia. Sci. World J. 2014, 2014, 698178. [Google Scholar] [CrossRef] [PubMed]
- Stein, S.E. An integrated method for spectrum extraction and compound identification from gas chromatography/mass spectrometry data. J. Am. Soc. Mass Spectrom. 1999, 10, 770–781. [Google Scholar] [CrossRef]
- Babushkina, E.A.; Belokopytova, L.V.; Grachev, A.M.; Meko, D.M.; Vaganov, E.A. Variation of the hydrological regime of Bele-Shira closed basin in Southern Siberia and its reflection in the radial growth of Larix sibirica. Reg. Environ. Change Metabol. 2018, 17, 1725–1737. [Google Scholar] [CrossRef]
- Bachmann, B.O.; Van Lanen, S.G.; Baltz, R.H. Microbial genome mining for accelerated natural products discovery: Is a renaissance in the making? Ind. Microbiol. Biotech. 2014, 41, 175–184. [Google Scholar] [CrossRef]
- Arulprakasam, K.R.; Dharumadurai, D. Genome mining of biosynthetic gene clusters intended for secondary metabolites conservation in actinobacteria. Microb. Pathog. 2021, 161, 105252. [Google Scholar] [CrossRef]
- Ling, L.L.; Schneider, T.; Peoples, A.J.; Spoering, A.L.; Engels, I.; Conlon, B.P.; Lewis, K. A new antibiotic kills pathogens without detectable resistance. Nature 2015, 517, 455–459. [Google Scholar] [CrossRef]
- Guo, C.; Mandalapu, D.; Ji, X.; Gao, J.; Zhang, Q. Chemistry and biology of teixobactin. Chem. A Eur. J. 2017, 24, 5406–5422. [Google Scholar] [CrossRef]
- Hover, B.M.; Kim, S.H.; Katz, M.; Charlop-Powers, Z.; Owen, J.G.; Ternei, M.A.; Maniko, J.; Estrela, A.B.; Molina, H.; Park, S.; et al. Culture-independent discovery of the malacidins as calcium-dependent antibiotics with activity against multidrug-resistant Gram-positive pathogens. Nat. Microbiol. 2018, 3, 415–422. [Google Scholar] [CrossRef]
- Wu, C.; Shang, Z.; Lemetre, C.; Ternei, M.A.; Brady, S.F. Cadasides, calcium-dependent acidic lipopeptides from the soil metagenome that are active against multidrug-resistant bacteria. J. Am. Chem. Soc. 2019, 141, 3910–3919. [Google Scholar] [CrossRef]
- Guerrero-Garzón, J.F.; Zehl, M.; Schneider, O.; Rückert, C.; Busche, T.; Kalinowski, J.; Bredholt, H.; Zotchev, S.B. Streptomyces spp. from the marine sponge Antho dichotoma: Analyses of secondary metabolite biosynthesis gene clusters and some of their products. Front. Microbiol. 2020, 11, 437. [Google Scholar] [CrossRef]
- Naughton, L.M.; Romano, S.; O’Gara, F.; Dobson, A.D. Identification of secondary metabolite gene clusters in the Pseudo vibrio genus reveals encouraging biosynthetic potential toward the production of novel bioactive compounds. Front. Microbiol. 2017, 8, 1494. [Google Scholar] [CrossRef]
- Belknap, K.C.; Park, C.J.; Barth, B.M.; Andam, C.P. Genome mining of biosynthetic and chemotherapeutic gene clusters in Streptomyces bacteria. Sci. Rep. 2020, 10, 1–9. [Google Scholar] [CrossRef]
- Liu, Y.; Chen, X.; Li, Z.; Xu, W.; Tao, W.; Wu, J.; Sun, Y. Functional analysis of cytochrome P450s involved in streptovaricin biosynthesis and generation of anti-MRSA analogues. ACS Chem. Biol. 2017, 12, 2589–2597. [Google Scholar] [CrossRef]
- Zhao, H.; Wang, L.; Wan, D.; Qi, J.; Gong, R.; Deng, Z.; Chen, W. Characterization of the aurantimycin biosynthetic gene cluster and enhancing its production by manipulating two pathway-specific activators in Streptomyces aurantiacus JA 4570. Microb. Cell Fact. 2016, 15, 160. [Google Scholar] [CrossRef][Green Version]
- Liu, W.T.; Lamsa, A.; Wong, W.R.; Boudreau, P.D.; Kersten, R.; Peng, Y.; Dorrestein, P.C. MS/MS-based networking and peptidogenomics guided genome mining revealed the stenothricin gene cluster in Streptomyces roseosporus. J. Antibiot. 2014, 67, 99–104. [Google Scholar] [CrossRef]
- Zheng, D.; Ding, N.; Jiang, Y.; Zhang, J.; Ma, J.; Chen, X.; Huang, X. Albaflavenoid, a new tricyclic sesquiterpenoid from Streptomyces violascens. J. Antibiot. 2016, 69, 773–775. [Google Scholar] [CrossRef]
- Belousoff, M.J.; Shapira, T.; Bashan, A.; Zimmerman, E.; Rozenberg, H.; Arakawa, K.; Yonath, A. Crystal structure of the synergistic antibiotic pair, lankamycin and lankacidin, in complex with the large ribosomal subunit. Proc. Natl. Acad. Sci. USA 2011, 108, 2717–2722. [Google Scholar] [CrossRef] [PubMed]
- Harada, S. Studies on Lankacidine-Group (T-2636) Antibiotics. VI. Chemical Structures of Lankacidin-Group Antibiotics. II. Chem. Pharm. Bull. 1975, 23, 2201–2210. [Google Scholar] [CrossRef] [PubMed]
- Rateb, M.E.; Houssen, W.E.; Arnold, M.; Abdelrahman, M.H.; Deng, H.; Harrison, W.T.; Jaspars, M. Chaxamycins A–D, bioactive ansamycins from a hyper-arid desert Streptomyces sp. J. Nat. Prod. 2011, 74, 1491–1499. [Google Scholar] [CrossRef] [PubMed]
- Corcilius, L.; Elias, N.T.; Ochoa, J.L.; Linington, R.G.; Payne, R.J. Total Synthesis of Glycinocins A–C. J. Org. Chem. 2017, 82, 12778–12785. [Google Scholar] [CrossRef] [PubMed]
- Cheng, P.; Xu, K.; Chen, Y.C.; Wang, T.T.; Chen, Y.; Yang, C.L.; Jiao, R.H. Cytotoxic aromatic polyketides from an insect derived Streptomyces sp. NA4286. Tetrahedron Lett. 2019, 60, 1706–1709. [Google Scholar] [CrossRef]
- He, X.; Li, M.; Song, S.; Wu, X.; Zhang, J.; Wu, G.; Zhang, H. Ficellomycin: An aziridine alkaloid antibiotic with potential therapeutic capacity. Appl. Microbiol. Biotechnol. 2018, 102, 4345–4354. [Google Scholar] [CrossRef]
- Sakoulas, G.; Nam, S.J.; Loesgen, S.; Fenical, W.; Jensen, P.R.; Nizet, V.; Hensler, M. Novel bacterial metabolite merochlorin A demonstrates in vitro activity against multi-drug resistant methicillin-resistant Staphylococcus aureus. PLoS ONE 2012, 7, e29439. [Google Scholar] [CrossRef]
- Deng, M.R.; Li, Y.; Luo, X.; Zheng, X.L.; Chen, Y.; Zhang, Y.L.; Zhu, H. Discovery of Mycothiogranaticins from Streptomyces vietnamensis GIMV4. 0001 and the Regulatory Effect of Mycothiol on the Granaticin Biosynthesis. Front. Chem. 2021, 9, 802279. [Google Scholar] [CrossRef]
- Lee, H.S.; An, B.J.; Kim, H.J.; Cho, Y.H.; Kim, D.I.; Jang, J.Y.; Shin, H.J. Anti-Inflammatory Effect of Violapyrones B and C from a Marine-derived Streptomyces sp. Nat. Prod. Sci. 2015, 21, 251–254. [Google Scholar] [CrossRef]
- Hou, L.; Huang, H.; Li, H.; Wang, S.; Ju, J.; Li, W. Overexpression of a type III PKS gene affording novel violapyrones with enhanced anti-influenza A virus activity. Microb. Cell Fact. 2018, 17, 61. [Google Scholar] [CrossRef]
- Son, S.; Hong, Y.S.; Jang, M.; Heo, K.T.; Lee, B.; Jang, J.P.; Ahn, J.S. Genomics-driven discovery of chlorinated cyclic hexapeptides ulleungmycins A and B from a Streptomyces species. J. Nat. Prod. 2017, 80, 3025–3031. [Google Scholar] [CrossRef]
- Xie, Y.; Ma, J.; Qin, X.; Li, Q.; Ju, J. Identification and utilization of two important transporters: SgvT1 and SgvT2, for griseoviridin and viridogrisein biosynthesis in Streptomyces griseoviridis. Microb. Cell Fact. 2017, 16, 177. [Google Scholar] [CrossRef]
- Lowell, A.N.; DeMars, M.D.; Slocum, S.T.; Yu, F.; Anand, K.; Chemler, J.A.; Sherman, D.H. Chemoenzymatic Total Synthesis and Structural Diversification of Tylactone-Based Macrolide Antibiotics through Late-Stage Polyketide Assembly, Tailoring, and C-H Functionalization. J. Am. Chem. Soc. 2017, 139, 7913–7920. [Google Scholar] [CrossRef] [PubMed]
- Hotta, K. Basic and applied research on multiple aminoglycoside antibiotic resistance of actinomycetes: An old-timer′s recollection. J. Ind. Microbiol. Biotechnol. 2021, 48, kuab059. [Google Scholar] [CrossRef]
- Fiedler, H.P. Abyssomicins—A 20-Year Retrospective View. Mar. Drugs 2021, 19, 299. [Google Scholar] [CrossRef] [PubMed]
- Liu, X.F.; Xiang, L.; Zhou, Q.; Carralot, J.P.; Prunotto, M.; Niederfellner, G.; Pastan, I. Actinomycin D enhances killing of cancer cells by immunotoxin RG7787 through activation of the extrinsic pathway of apoptosis. Proc. Natl. Acad. Sci. USA 2016, 113, 10666–10671. [Google Scholar] [CrossRef]
- Gionfriddo, I.; Brunetti, L.; Mezzasoma, F.; Milano, F.; Cardinali, V.; Ranieri, R.; Falini, B. Dactinomycin induces complete remission associated with nucleolar stress response in relapsed/refractory NPM1-mutated AML. Leukemia 2021, 35, 2552–2562. [Google Scholar] [CrossRef]
- Li, R.; Lloyd, E.P.; Moshos, K.A.; Townsend, C.A. Identification and characterization of the carbapenem MM 4550 and its gene cluster in Streptomyces argenteolus ATCC 11009. ChemBioChem 2014, 15, 320–331. [Google Scholar] [CrossRef][Green Version]
- Schulze, C.J.; Bray, W.M.; Loganzo, F.; Lam, M.H.; Szal, T.; Villalobos, A.; Linington, R.G. Borrelidin B: Isolation, biological activity, and implications for nitrile biosynthesis. J. Nat. Prod. 2014, 77, 2570–2574. [Google Scholar] [CrossRef] [PubMed]
- Bae, M.; Chung, B.; Oh, K.B.; Shin, J.; Oh, D.C. Hormaomycins B and C: New antibiotic cyclic depsipeptides from a marine mudflat-derived Streptomyces sp. Mar. Drugs 2015, 13, 5187–5200. [Google Scholar] [CrossRef] [PubMed]
- Mojićević, M.; Grahovac, J.; Petković, M.; Vučković, I.; Dodić, J.; Dodić, S.; Vojnović, S. Production of nigericin and niphimycin by soil isolate Streptomyces sp. Ms1: Anti-Candida bioassay guided response surface methodology for the optimized culture medium. Facta Univ. Ser. Phys. Chem. Technol. 2017, 15, 1–16. [Google Scholar] [CrossRef][Green Version]
- Fang, X.; Tiyanont, K.; Zhang, Y.; Wanner, J.; Boger, D.; Walker, S. The mechanism of action of ramoplanin and enduracidin. Mol. BioSyst. 2006, 2, 69–76. [Google Scholar] [CrossRef]
- Chen, Y.W.; Liu, X.C.; Lv, F.X.; Li, P. Characterization of three regulatory genes involved in enduracidin biosynthesis and improvement of enduracidin production in Streptomyces fungicidicus. J. Appl. Microbiol. 2019, 127, 1698–1705. [Google Scholar] [CrossRef]
- Boros, C.; Smith, C.J.; Vasina, Y.; Che, Y.; Dix, A.B.; Darveaux, B.; Pearce, C. Isolation and Identification of the Icosalides--Cyclic Peptolides with Selective Antibiotic and Cytotoxic Activities. J. Antibiot. 2006, 59, 486–494. [Google Scholar] [CrossRef]
- Phelan, J.J.; McQuaid, K.; Kenny, C.; Gogan, K.M.; Cox, D.J.; Basdeo, S.A.; Keane, J. Desferrioxamine supports metabolic function in primary human macrophages infected with Mycobacterium tuberculosis. Front. Immunol. 2020, 11, 836. [Google Scholar] [CrossRef]
- Greule, A.; Marolt, M.; Deubel, D.; Peintner, I.; Zhang, S.; Jessen-Trefzer, C.; Bechthold, A. Wide Distribution of Foxicin Biosynthetic Gene Clusters in Streptomyces Strains–An Unusual Secondary Metabolite with Various Properties. Front. Microbiol. 2017, 8, 221. [Google Scholar] [CrossRef]
- Du, Y.; Wang, Y.; Huang, T.; Tao, M.; Deng, Z.; Lin, S. Identification and characterization of the biosynthetic gene cluster of polyoxypeptin A, a potent apoptosis inducer. BMC Microbiol. 2014, 14, 30. [Google Scholar] [CrossRef]
- Shi, J.; Zeng, Y.J.; Zhang, B.; Shao, F.L.; Chen, Y.C.; Xu, X.; Ge, H.M. Comparative genome mining and heterologous expression of an orphan NRPS gene cluster direct the production of ashimides. Chem. Sci. 2019, 10, 3042–3048. [Google Scholar] [CrossRef]
- Ghosh, A.K.; Allu, S.R.; Reddy, G.C.; Lopez, A.G.; Mendez, P.; Jurica, M.S. Design and synthesis of herboxidiene derivatives that potently inhibit in vitro splicing. Org. Biomol. Chem. 2021, 19, 1365–1377. [Google Scholar] [CrossRef] [PubMed]
- Stankovic, N.; Senerovic, L.; Ilic-Tomic, T.; Vasiljevic, B.; Nikodinovic-Runic, J. Properties and applications of undecylprodigiosin and other bacterial prodigiosins. Appl. Microbiol. Biotechnol. 2014, 98, 3841–3858. [Google Scholar] [CrossRef]
- Choi, Y.H.; Sohn, J.H.; Lee, D.; Kim, J.K.; Kong, I.S.; Ahn, S.C.; Oh, H. Chejuenolides A and B, new macrocyclic tetraenes from the marine bacterium Hahella chejuensis. Tetrahedron Lett. 2008, 49, 7128–7131. [Google Scholar] [CrossRef]
- Thaker, M.N.; Wang, W.; Spanogiannopoulos, P.; Waglechner, N.; King, A.M.; Medina, R.; Wright, G.D. Identifying producers of antibacterial compounds by screening for antibiotic resistance. Nat. Biotechnol. 2013, 31, 922–927. [Google Scholar] [CrossRef] [PubMed]
- Bibikova, M.V.; Ivanitskaia, L.P.; Singal, E.M. Directed screening of aminoglycoside antibiotic producers on selective media with gentamycin. Antibiotiki 1981, 26, 488–492. [Google Scholar] [PubMed]
- Ivanitskaia, L.P.; Bibikova, M.V.; Gromova, M.N.; IuV, Z.; Istratov, E.N. Use of selective media with lincomycin for the directed screening of antibiotic producers. Antibiotiki 1981, 26, 83–86. [Google Scholar] [PubMed]
- Yim, G.; Wang, H.H. Davies, J. Antibiotics as signaling molecules. Phil. Trans. R. Soc. B 2007, 362, 1195–1200. [Google Scholar] [CrossRef] [PubMed]
Disclaimer/Publisher’s Note: The statements, opinions and data contained in all publications are solely those of the individual author(s) and contributor(s) and not of MDPI and/or the editor(s). MDPI and/or the editor(s) disclaim responsibility for any injury to people or property resulting from any ideas, methods, instructions or products referred to in the content. |
© 2023 by the authors. Licensee MDPI, Basel, Switzerland. This article is an open access article distributed under the terms and conditions of the Creative Commons Attribution (CC BY) license (https://creativecommons.org/licenses/by/4.0/).